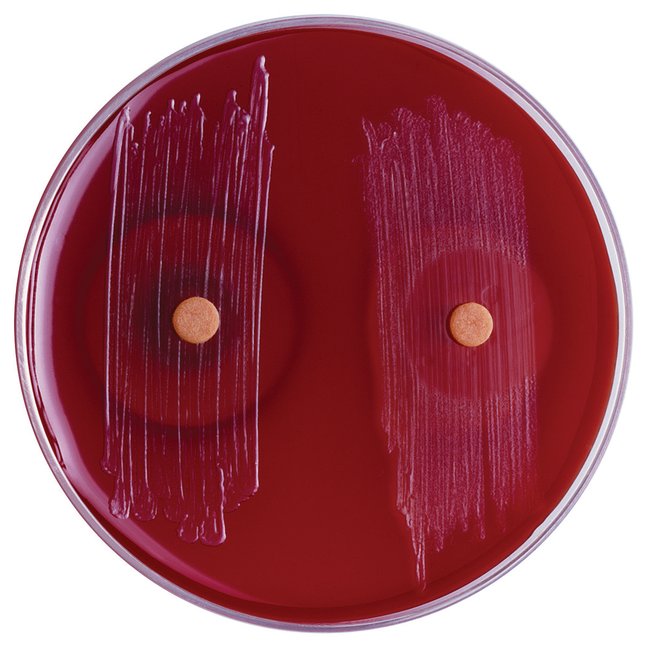

Bile Disc, Bile Disc Is Used As A Screening Test To Separate Bacteroides Fragilis From Other Gram-Negative Anaerobic Bacilli, Pack Of 25
$ 241.65
|
|
Details:
Thermo Scientific™ Bile Disc is used as a screening test to separate Bacteroides fragilis from other gram-negative anaerobic bacilli.
Additional Information
| SKU | 1106276 |
|---|---|
| UOM | Pack of 25 |
| UNSPSC | 41121806 |
| Manufacturer Part Number | R21122 |
